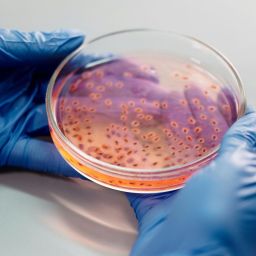
evento europeu de biotecnologia

É um livro único, que fala sobre um tema também ele único e raro. Porque é ainda muito o desconhecimento sobre as doenças raras, a P-BIO – Associação Portuguesa de Empresas de Bioindústria, que reúne várias empresas ligadas ao setor da biotecnologia e lifescience, prepara-se para apresentar o Livro Branco das Doenças Raras e dos Medicamentos Órfãos em Portugal.
Será no dia 27 de fevereiro, entre as 15h00 e as 17h00, no Auditório do INFARMED, em Lisboa, que será feita a apresentação pública deste livro, que conta com a colaboração de vários especialistas sobre temas como a epidemiologia das doenças raras, os testes genéticos na prática clínica, os centros de referência, a investigação e onde se é dada ainda voz ao doente.
São vários os Grupos de Trabalho, dedicados a várias áreas, que fazem parte da P-BIO. Um deles é o grupo dedicado às Doenças Raras e Medicamentos Órfãos, que identificou uma lacuna no conhecimento agregado sobre as doenças raras e os medicamentos destinados ao seu tratamento em Portugal.
Motivo para a criação deste Livro Branco, que procura juntar o conjunto das áreas temáticas consideradas mais relevantes para uma visão integrada do problema das doenças órfãs, convocando, para isso, o contributo de especialistas experientes, sob a coordenação do Francisco Batel Marques, professor da Faculdade de Farmácia da Universidade de Coimbra e diretor do Centro de Avaliação de Tecnologias da Saúde e Investigação do Medicamento.
É esta obra que se pretende apresentar ao público especializado e, ao mesmo tempo, aproveitar para criar um momento de reflexão e de discussão sobre os novos caminhos, desafios e oportunidades para o futuro no que diz respeito a estas doenças.
As inscrições pode ser feitas aqui.